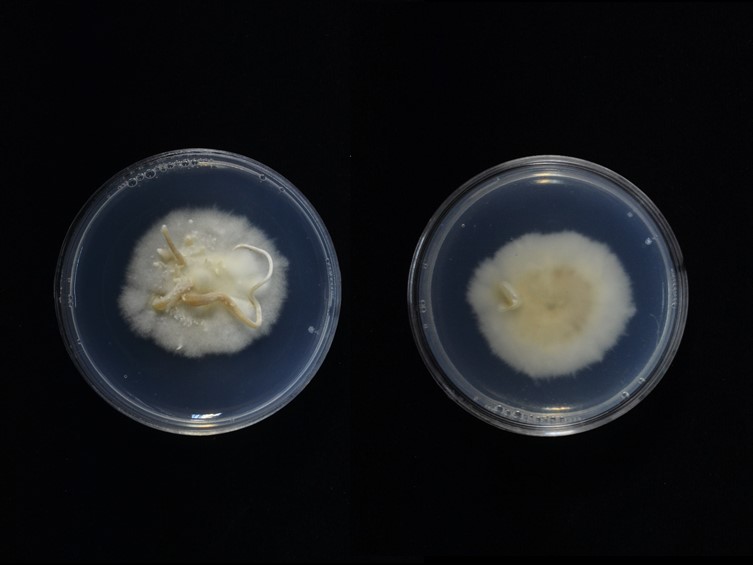

Holotype:
THAILAND, Kanchanaburi Province, 20 Jun. 1995, Hywel-Jones NL, Nasit R,Sivichai S, holotype BBH5634, ex-type living culture BCC 1920.
Habitat:
Buried in soil.
Host:
On Termites.
Description:

Stromata solitary, simple, filiform, up to 14 cm long, 1 mm wide, yellow-brown, ca. 6 cm emerging above the leaf litter, ca. 8 cm buried in the soil. 
Perithecia pseudo-immersed, globose to subglobose, produced on one-third of the terminal part of the stroma ending near the apex, 200–280 × 150–250 μm. 
Asci 8-spored, filiform, 62–110 × 4–6 μm. Ascospores whole, filiform, 85 × 2 μm. Asexual morph: Hymenostilbe produced ca. 1 cm at the terminal part of the stroma, grey. 
Conidiogenous cells formed a compact hymenium-like layer and had from two to four denticles at their apices, cylindrical to clavate, 10–17 × 3–6 μm. 
Conidia hyaline, fusiform 7 × 3 μm.
Culture characteristics:
Colonies on PDA attaining a diam of 28 mm in 20 d, grey to pale grey. 
Conidiogenous cells monophialidic to polyphialidic, arising from hyphae laterally, with an inflated base, 7–11 × 2.5–4 μm. 
Conidia hyaline, globose, one-celled with warty surface, 2.5–3.5 μm.
Reference:
Tasanathai K, Noisripoom W, Chaitika T, et al. (2019). Phylogenetic and morphological classification of Ophiocordyceps species on termites from Thailand. MycoKeys 56: 101–129.
DOI: https://doi.org/10.3897/mycokeys.56.37636Species |
Strain |
Compound |
Pubchem CID |
Biological activity |
Reference |
|---|
|
Strain |
GU723780 | MH754724 | MZ676748 |
|---|---|---|---|
| BCC 1770 | MH753677 | - | - |
| BCC 1920 | - | MH753678 | - |
| BCC 93002 | - | - | MZ675427 |